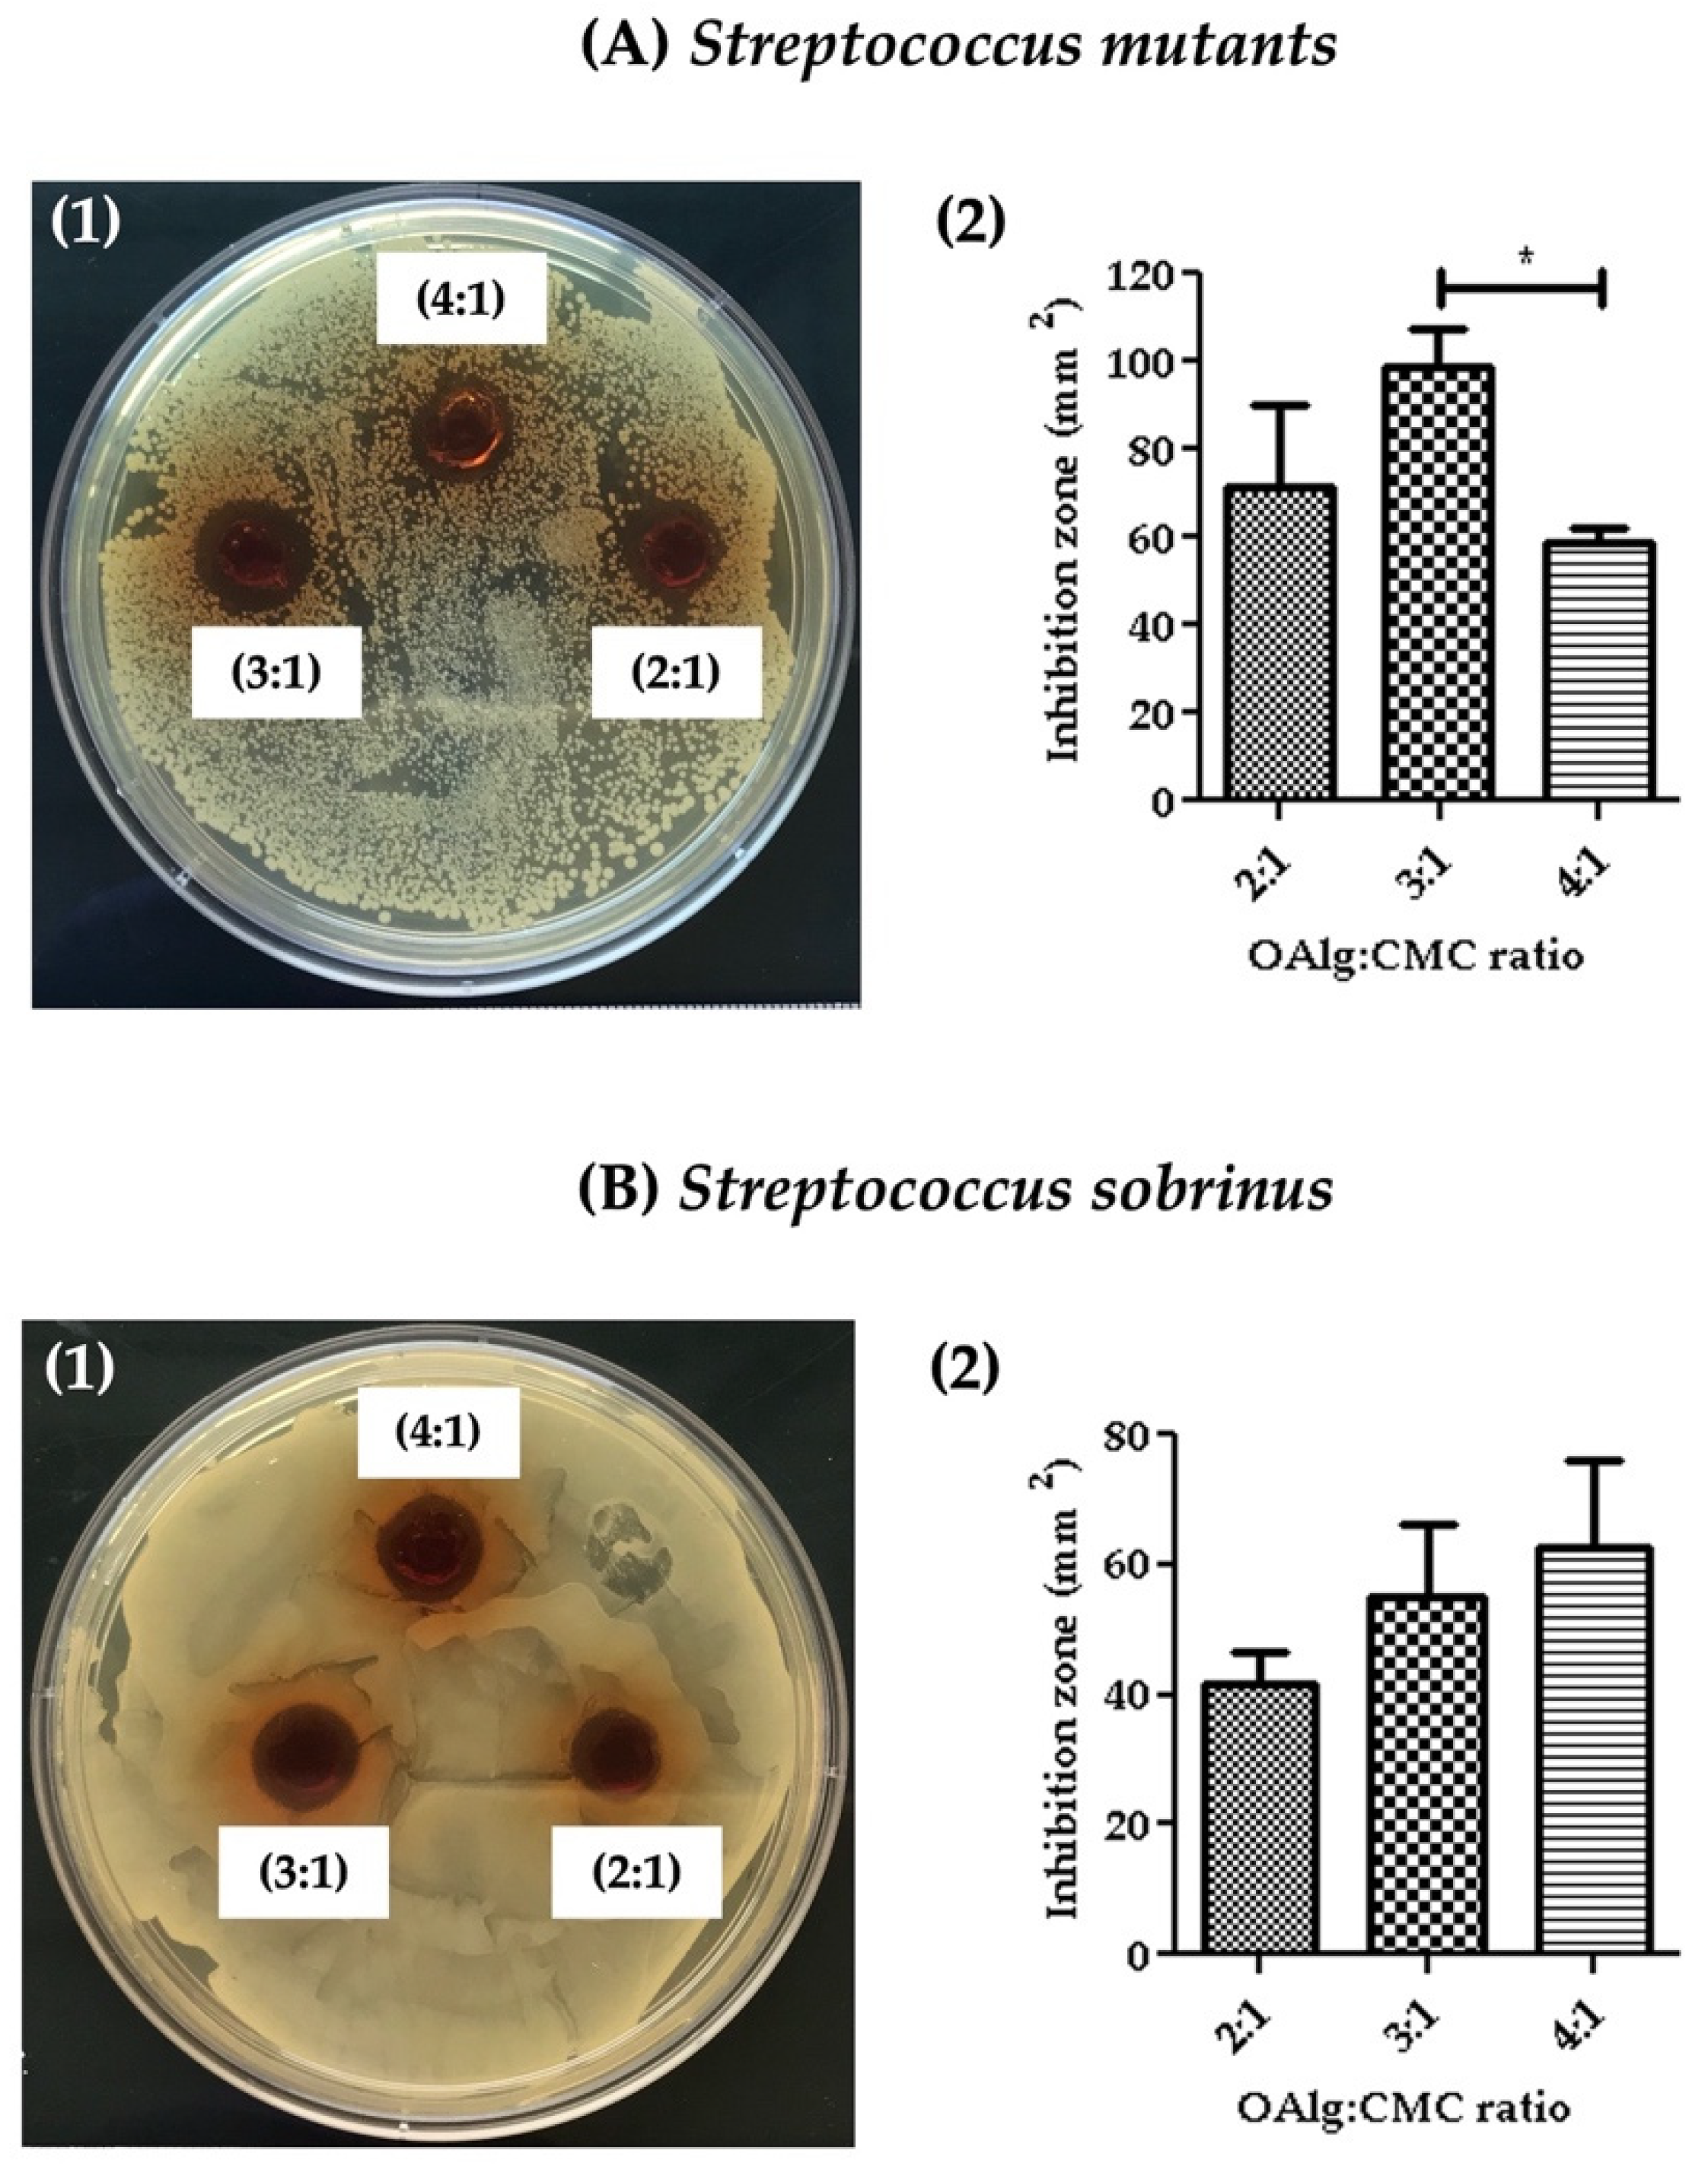
Jfb 13 00071 g007

Self-Crosslinkable Oxidized Alginate-Carboxymethyl Chitosan Hydrogels as an Injectable Cell Carrier for In Vitro Dental Enamel Regeneration
Abstract
:1. Introduction
2. Materials and Methods
2.1. Synthesis of Oxidized Alginate
2.2. Determination of the Oxidation Degree
2.3. Self-Crosslinkable Hydrogel Formation
2.4. Gelation Time
2.5. Chemical Characterization of Self-Crosslinked Hydrogels
2.6. Swelling Test
2.7. Microstructural Observation of the Self-Crosslinkable Hydrogels
2.8. Injectability and Self-Healing Assays
2.9. Antibacterial Properties
2.10. In Vitro Evaluations of Self-Crosslinkable Hydrogels
2.10.1. Cell Culture
2.10.2. Cell Encapsulation in Self-Crosslinkable Hydrogels
2.10.3. Cell Viability Assessment
2.10.4. Alkaline Phosphatase Staining
2.10.5. Alizarin Red S Staining
2.10.6. Observation of Cell Morphologies in the Self-Crosslinked Hydrogels
2.11. Statistical Analysis
3. Results
3.1. Comparative Chemical Characterization of Synthesized Oxidized Alginate and Alginate Confirmed the Modification of Alginate with Aldehyde Groups
3.2. The Experimental Oxidation Degree of Alginate as a Representation of Available Aldehyde Groups for Schiff Based Reaction Was Found to Be Close to the Theoretical Oxidation Degree
3.3. Comparative Chemical Characterization of Hydrogel and Alginate and Carboxymethyl Chitosan Confirmed the Formation Self-Crosslinkable Hydrogel through Schiff Base Reaction
3.4. Hydrogels with Higher the OAlg:CMC Ratio Showed Faster Gelation Time
3.5. Hydrogels with Higher the OAlg:CMC Ratio Showed Lower Swelling Ability
3.6. Morphological Characterization of Self-Crosslinked Hydrogels
3.7. Injectability and Self-Healing Properties
3.8. Assessment of Antibacterial Properties
3.9. Live/Dead Assay
3.10. Mineralization Assays
3.11. SEM Analysis of Cell-Laden Hydrogels
4. Discussion
5. Conclusions
Author Contributions
Funding
Data Availability Statement
Conflicts of Interest
References
- Kim, D.; Barraza, J.P.; Arthur, R.A.; Hara, A.; Lewis, K.; Liu, Y.; Scisci, E.L.; Hajishengallis, E.; Whiteley, M.; Koo, H. Spatial mapping of polymicrobial communities reveals a precise biogeography associated with human dental caries. Proc. Natl. Acad. Sci. USA 2020, 117, 12375–12386. [Google Scholar] [CrossRef]
- Qiu, W.; Zhou, Y.; Li, Z.; Huang, T.; Xiao, Y.; Cheng, L.; Peng, X.; Zhang, L.; Ren, B. Application of antibiotics/antimicrobial agents on dental caries. Biomed Res. Int. 2020, 2020, 5658212. [Google Scholar] [CrossRef] [PubMed] [Green Version]
- Binder, M.; Biggs, L.C.; Kronenberg, M.S.; Schneider, P.; Thesleff, I.; Balic, A. Novel strategies for expansion of tooth epithelial stem cells and ameloblast generation. Sci. Rep. 2020, 10, 4963. [Google Scholar] [CrossRef] [PubMed] [Green Version]
- Honda, M.J.; Shinmura, Y.; Shinohara, Y. Enamel tissue engineering using subcultured enamel organ epithelial cells in combination with dental pulp cells. Cells Tissues Organs 2009, 189, 261–267. [Google Scholar] [CrossRef]
- Yazdanian, M.; Arefi, A.H.; Alam, M.; Abbasi, K.; Tebyaniyan, H.; Tahmasebi, E.; Ranjbar, R.; Seifalian, A.; Yazdanian, A. Decellularized and biological scaffolds in dental and craniofacial tissue engineering: A comprehensive overview. J. Mater. Res. Technol. 2021, 15, 1217–1251. [Google Scholar] [CrossRef]
- Chatzistavrou, X.; Papagerakis, S.; Ma, P.X.; Papagerakis, P. Innovative approaches to regenerate enamel and dentin. Int. J. Dent. 2012, 2012, 856470. [Google Scholar] [CrossRef] [Green Version]
- Rosa, V.; Della Bona, A.; Cavalcanti, B.N.; Nör, J.E. Tissue engineering: From research to dental clinics. Dent. Mater. 2012, 28, 341–348. [Google Scholar] [CrossRef] [PubMed] [Green Version]
- Dong, Q.; Wang, Y.; Mohabatpour, F.; Zheng, L.; Papagerakis, S.; Chen, D.; Papagerakis, P. Dental Pulp Stem Cells: Isolation, Characterization, Expansion, and Odontoblast Differentiation for Tissue Engineering. In Odontogenesis; Springer: Cham, Switzerland, 2019; pp. 91–101. [Google Scholar]
- Fang, Z.; Guo, M.; Zhou, Q.; Li, Q.; Wong, H.M.; Cao, C.Y. Enamel-like tissue regeneration by using biomimetic enamel matrix proteins. Int. J. Biol. Macromol. 2021, 183, 2131–2141. [Google Scholar] [CrossRef]
- Duailibi, M.T.; Duailibi, S.E.; Dantas, F.M.L.; Yelick, P.C. Scaffolds that promote enamel remineralization. In Handbook of Tissue Engineering Scaffolds: Volume One; Elsevier: Amsterdam, The Netherlands, 2019; pp. 545–562. [Google Scholar]
- Mukherjee, K.; Ruan, Q.; Liberman, D.; White, S.N.; Moradian-Oldak, J. Repairing human tooth enamel with leucine-rich amelogenin peptide–chitosan hydrogel. J. Mater. Res. 2016, 31, 556–563. [Google Scholar] [CrossRef] [Green Version]
- Fang, R.; Tian, W.; Chen, X. Synthesis of injectable alginate hydrogels with muscle-derived stem cells for potential myocardial infarction repair. Appl. Sci. 2017, 7, 252. [Google Scholar] [CrossRef] [Green Version]
- Qiao, S.; Zhao, Y.; Li, C.; Yin, Y.; Meng, Q.; Lin, F.-H.; Liu, Y.; Hou, X.; Guo, K.; Chen, X. An alginate-based platform for cancer stem cell research. Acta Biomater. 2016, 37, 83–92. [Google Scholar] [CrossRef] [PubMed]
- Fang, R.; Qiao, S.; Liu, Y.; Meng, Q.; Chen, X.; Song, B.; Hou, X.; Tian, W. Sustained co-delivery of BIO and IGF-1 by a novel hybrid hydrogel system to stimulate endogenous cardiac repair in myocardial infarcted rat hearts. Int. J. Nanomed. 2015, 10, 4691. [Google Scholar] [CrossRef] [PubMed]
- Bai, X.; Fang, R.; Zhang, S.; Shi, X.; Wang, Z.; Chen, X.; Yang, J.; Hou, X.; Nie, Y.; Li, Y. Self-cross-linkable hydrogels composed of partially oxidized alginate and gelatin for myocardial infarction repair. J. Bioact. Compat. Polym. 2013, 28, 126–140. [Google Scholar] [CrossRef]
- Chang, B.; Ahuja, N.; Ma, C.; Liu, X. Injectable scaffolds: Preparation and application in dental and craniofacial regeneration. Mater. Sci. Eng. R Rep. 2017, 111, 1–26. [Google Scholar] [CrossRef] [Green Version]
- Toh, W. Injectable hydrogels in dentistry: Advances and promises. Austin J. Dent. 2014, 1, 1001. [Google Scholar]
- Haugen, H.J.; Basu, P.; Sukul, M.; Mano, J.F.; Reseland, J.E. Injectable Biomaterials for Dental Tissue Regeneration. Int. J. Mol. Sci. 2020, 21, 3442. [Google Scholar] [CrossRef] [PubMed]
- Amini, A.A.; Nair, L.S. Injectable hydrogels for bone and cartilage repair. Biomed. Mater. 2012, 7, 24105. [Google Scholar] [CrossRef]
- Liu, C.; Zhang, Q.; Zhu, S.; Liu, H.; Chen, J. Preparation and applications of peptide-based injectable hydrogels. RSC Adv. 2019, 9, 28299–28311. [Google Scholar] [CrossRef] [Green Version]
- Nguyen, Q.V.; Park, J.H.; Lee, D.S. Injectable polymeric hydrogels for the delivery of therapeutic agents: A review. Eur. Polym. J. 2015, 72, 602–619. [Google Scholar] [CrossRef]
- Mathew, A.P.; Uthaman, S.; Cho, K.-H.; Cho, C.-S.; Park, I.-K. Injectable hydrogels for delivering biotherapeutic molecules. Int. J. Biol. Macromol. 2018, 110, 17–29. [Google Scholar] [CrossRef]
- Ma, L.; Su, W.; Ran, Y.; Ma, X.; Yi, Z.; Chen, G.; Chen, X.; Deng, Z.; Tong, Q.; Wang, X. Synthesis and characterization of injectable self-healing hydrogels based on oxidized alginate-hybrid-hydroxyapatite nanoparticles and carboxymethyl chitosan. Int. J. Biol. Macromol. 2020, 165, 1164–1174. [Google Scholar] [CrossRef] [PubMed]
- Naghizadeh, Z.; Karkhaneh, A.; Khojasteh, A. Self-crosslinking effect of chitosan and gelatin on alginate based hydrogels: Injectable in situ forming scaffolds. Mater. Sci. Eng. C 2018, 89, 256–264. [Google Scholar] [CrossRef] [PubMed]
- Talebian, S.; Mehrali, M.; Taebnia, N.; Pennisi, C.P.; Kadumudi, F.B.; Foroughi, J.; Hasany, M.; Nikkhah, M.; Akbari, M.; Orive, G. Self-healing hydrogels: The next paradigm shift in tissue engineering? Adv. Sci. 2019, 6, 1801664. [Google Scholar] [CrossRef] [Green Version]
- Wei, Z.; Zhao, J.; Chen, Y.M.; Zhang, P.; Zhang, Q. Self-healing polysaccharide-based hydrogels as injectable carriers for neural stem cells. Sci. Rep. 2016, 6, 37841. [Google Scholar] [CrossRef] [PubMed] [Green Version]
- Pathan, N.; Shende, P. Strategic conceptualization and potential of self-healing polymers in biomedical field. Mater. Sci. Eng. C 2021, 125, 112099. [Google Scholar] [CrossRef] [PubMed]
- Ding, F.; Wu, S.; Wang, S.; Xiong, Y.; Li, Y.; Li, B.; Deng, H.; Du, Y.; Xiao, L.; Shi, X. A dynamic and self-crosslinked polysaccharide hydrogel with autonomous self-healing ability. Soft Matter 2015, 11, 3971–3976. [Google Scholar] [CrossRef]
- Fan, L.; Pan, X.; Zhou, Y.; Chen, L.; Xie, W.; Long, Z.; Zheng, H. Preparation and characterization of crosslinked carboxymethyl chitosan–oxidized sodium alginate hydrogels. J. Appl. Polym. Sci. 2011, 122, 2331–2337. [Google Scholar] [CrossRef]
- Naghieh, S.; Sarker, M.D.; Sharma, N.K.; Barhoumi, Z.; Chen, X. Printability of 3D printed hydrogel scaffolds: Influence of hydrogel composition and printing parameters. Appl. Sci. 2020, 10, 292. [Google Scholar] [CrossRef] [Green Version]
- Chen, D.X.B. Extrusion Bioprinting of Scaffolds for Tissue Engineering Applications; Springer: Cham, Switzerland, 2019. [Google Scholar]
- Baniasadi, H.; Mashayekhan, S.; Fadaoddini, S.; Haghirsharifzamini, Y. Design, fabrication and characterization of oxidized alginate–gelatin hydrogels for muscle tissue engineering applications. J. Biomater. Appl. 2016, 31, 152–161. [Google Scholar] [CrossRef]
- Soltan, N.; Ning, L.; Mohabatpour, F.; Papagerakis, P.; Chen, X. Printability and cell viability in bioprinting alginate dialdehyde-gelatin scaffolds. ACS Biomater. Sci. Eng. 2019, 5, 2976–2987. [Google Scholar] [CrossRef]
- Shariatinia, Z. Carboxymethyl chitosan: Properties and biomedical applications. Int. J. Biol. Macromol. 2018, 120, 1406–1419. [Google Scholar] [CrossRef] [PubMed]
- Sadeghianmaryan, A.; Naghieh, S.; Yazdanpanah, Z.; Sardroud, H.A.; Sharma, N.K.; Wilson, L.D.; Chen, X. Fabrication of chitosan/alginate/hydroxyapatite hybrid scaffolds using 3D printing and impregnating techniques for potential cartilage regeneration. Int. J. Biol. Macromol. 2022, 204, 62–75. [Google Scholar] [CrossRef]
- Sadeghianmaryan, A.; Naghieh, S.; Sardroud, H.A.; Yazdanpanah, Z.; Soltani, Y.A.; Sernaglia, J.; Chen, X. Extrusion-based printing of chitosan scaffolds and their in vitro characterization for cartilage tissue engineering. Int. J. Biol. Macromol. 2020, 164, 3179–3192. [Google Scholar] [CrossRef] [PubMed]
- Bakhsheshi-Rad, H.R.; Ismail, A.F.; Aziz, M.; Akbari, M.; Hadisi, Z.; Omidi, M.; Chen, X. Development of the PVA/CS nanofibers containing silk protein sericin as a wound dressing: In vitro and in vivo assessment. Int. J. Biol. Macromol. 2020, 149, 513–521. [Google Scholar] [CrossRef] [PubMed]
- Palma, P.J.; Ramos, J.C.; Martins, J.B.; Diogenes, A.; Figueiredo, M.H.; Ferreira, P.; Viegas, C.; Santos, J.M. Histologic evaluation of regenerative endodontic procedures with the use of chitosan scaffolds in immature dog teeth with apical periodontitis. J. Endod. 2017, 43, 1279–1287. [Google Scholar] [CrossRef]
- Pandit, A.H.; Mazumdar, N.; Imtiyaz, K.; Alam Rizvi, M.M.; Ahmad, S. Self-healing and injectable hydrogels for anticancer drug delivery: A study with multialdehyde gum arabic and succinic anhydride chitosan. ACS Appl. Bio Mater. 2020, 3, 8460–8470. [Google Scholar] [CrossRef]
- Xu, H.; Zhang, L.; Cai, J. Injectable, self-healing, β-chitin-based hydrogels with excellent cytocompatibility, antibacterial activity, and potential as drug/cell carriers. ACS Appl. Bio Mater. 2018, 2, 196–204. [Google Scholar] [CrossRef]
- Luü, S.; Gao, C.; Xu, X.; Bai, X.; Duan, H.; Gao, N.; Feng, C.; Xiong, Y.; Liu, M. Injectable and self-healing carbohydrate-based hydrogel for cell encapsulation. ACS Appl. Mater. Interfaces 2015, 7, 13029–13037. [Google Scholar] [CrossRef]
- Li, Y.; Zhang, Y.; Shi, F.; Tao, L.; Wei, Y.; Wang, X. Modulus-regulated 3D-cell proliferation in an injectable self-healing hydrogel. Colloids Surf. B Biointerfaces 2017, 149, 168–173. [Google Scholar] [CrossRef]
- Qu, J.; Zhao, X.; Liang, Y.; Zhang, T.; Ma, P.X.; Guo, B. Antibacterial adhesive injectable hydrogels with rapid self-healing, extensibility and compressibility as wound dressing for joints skin wound healing. Biomaterials 2018, 183, 185–199. [Google Scholar] [CrossRef]
- Wang, K.; Dong, R.; Tang, J.; Li, H.; Dang, J.; Zhang, Z.; Yu, Z.; Guo, B.; Yi, C. Exosomes laden self-healing injectable hydrogel enhances diabetic wound healing via regulating macrophage polarization to accelerate angiogenesis. Chem. Eng. J. 2022, 430, 132664. [Google Scholar] [CrossRef]
- Sarker, B.; Papageorgiou, D.G.; Silva, R.; Zehnder, T.; Gul-E-Noor, F.; Bertmer, M.; Kaschta, J.; Chrissafis, K.; Detsch, R.; Boccaccini, A.R. Fabrication of alginate–gelatin crosslinked hydrogel microcapsules and evaluation of the microstructure and physico-chemical properties. J. Mater. Chem. B 2014, 2, 1470–1482. [Google Scholar] [CrossRef] [PubMed] [Green Version]
- You, F.; Wu, X.; Kelly, M.; Chen, X. Bioprinting and in vitro characterization of alginate dialdehyde–gelatin hydrogel bio-ink. Bio-Des. Manuf. 2020, 3, 48–59. [Google Scholar] [CrossRef] [Green Version]
- Peer, M.S.; Kasimani, R.; Rajamohan, S.; Ramakrishnan, P. Experimental evaluation on oxidation stability of biodiesel/diesel blends with alcohol addition by rancimat instrument and FTIR spectroscopy. J. Mech. Sci. Technol. 2017, 31, 455–463. [Google Scholar] [CrossRef]
- Gomez, C.G.; Rinaudo, M.; Villar, M.A. Oxidation of sodium alginate and characterization of the oxidized derivatives. Carbohydr. Polym. 2007, 67, 296–304. [Google Scholar] [CrossRef]
- Mousavi, A.; Mashayekhan, S.; Baheiraei, N.; Pourjavadi, A. Biohybrid oxidized alginate/myocardial extracellular matrix injectable hydrogels with improved electromechanical properties for cardiac tissue engineering. Int. J. Biol. Macromol. 2021, 180, 692–708. [Google Scholar] [CrossRef] [PubMed]
- Huang, W.; Wang, Y.; Huang, Z.; Wang, X.; Chen, L.; Zhang, Y.; Zhang, L. On-demand dissolvable self-healing hydrogel based on carboxymethyl chitosan and cellulose nanocrystal for deep partial thickness burn wound healing. ACS Appl. Mater. Interfaces 2018, 10, 41076–41088. [Google Scholar] [CrossRef] [PubMed]
- Huang, W.; Wang, Y.; Chen, Y.; Zhao, Y.; Zhang, Q.; Zheng, X.; Chen, L.; Zhang, L. Strong and rapidly self-healing hydrogels: Potential hemostatic materials. Adv. Healthc. Mater. 2016, 5, 2813–2822. [Google Scholar] [CrossRef]
- Li, H.; Cheng, F.; Wei, X.; Yi, X.; Tang, S.; Wang, Z.; Zhang, Y.S.; He, J.; Huang, Y. Injectable, self-healing, antibacterial, and hemostatic N, O-carboxymethyl chitosan/oxidized chondroitin sulfate composite hydrogel for wound dressing. Mater. Sci. Eng. C 2021, 118, 111324. [Google Scholar] [CrossRef]
- Kawano, S.; Morotomi, T.; Toyono, T.; Nakamura, N.; Uchida, T.; Ohishi, M.; Toyoshima, K.; Harada, H. Establishment of Dental Epithelial Cell Line (HAT-7) and the Cell Differentiation Dependent on Notch Signaling Pathway. Connect. Tissue Res. 2002, 43, 409–412. [Google Scholar] [CrossRef]
- Emami, Z.; Ehsani, M.; Zandi, M.; Foudazi, R. Controlling alginate oxidation conditions for making alginate-gelatin hydrogels. Carbohydr. Polym. 2018, 198, 509–517. [Google Scholar] [CrossRef]
- Park, J.; Nam, J.; Yun, H.; Jin, H.-J.; Kwak, H.W. Aquatic polymer-based edible films of fish gelatin crosslinked with alginate dialdehyde having enhanced physicochemical properties. Carbohydr. Polym. 2021, 254, 117317. [Google Scholar] [CrossRef] [PubMed]
- Wu, Y.; Yuan, L.; Sheng, N.; Gu, Z.; Feng, W.; Yin, H.; Morsi, Y.; Mo, X. A soft tissue adhesive based on aldehyde-sodium alginate and amino-carboxymethyl chitosan preparation through the Schiff reaction. Front. Mater. Sci. 2017, 11, 215–222. [Google Scholar] [CrossRef]
- Kurniasih, M.; Cahyati, T.; Dewi, R.S. Carboxymethyl chitosan as an antifungal agent on gauze. Int. J. Biol. Macromol. 2018, 119, 166–171. [Google Scholar] [CrossRef] [PubMed]
- Nguyen, T.-P.; Lee, B.-T. Fabrication of oxidized alginate-gelatin-BCP hydrogels and evaluation of the microstructure, material properties and biocompatibility for bone tissue regeneration. J. Biomater. Appl. 2012, 27, 311–321. [Google Scholar] [CrossRef]
- Liao, H.; Zhang, H.; Chen, W. Differential physical, rheological, and biological properties of rapid in situ gelable hydrogels composed of oxidized alginate and gelatin derived from marine or porcine sources. J. Mater. Sci. Mater. Med. 2009, 20, 1263–1271. [Google Scholar] [CrossRef]
- Conrads, G.; de Soet, J.J.; Song, L.; Henne, K.; Sztajer, H.; Wagner-Döbler, I.; Zeng, A.-P. Comparing the cariogenic species Streptococcus sobrinus and S. mutans on whole genome level. J. Oral Microbiol. 2014, 6, 26189. [Google Scholar] [CrossRef] [Green Version]
- Chen, H.; Xing, X.; Tan, H.; Jia, Y.; Zhou, T.; Chen, Y.; Ling, Z.; Hu, X. Covalently antibacterial alginate-chitosan hydrogel dressing integrated gelatin microspheres containing tetracycline hydrochloride for wound healing. Mater. Sci. Eng. C 2017, 70, 287–295. [Google Scholar] [CrossRef]
- Li, X.; Weng, Y.; Kong, X.; Zhang, B.; Li, M.; Diao, K.; Zhang, Z.; Wang, X.; Chen, H. A covalently crosslinked polysaccharide hydrogel for potential applications in drug delivery and tissue engineering. J. Mater. Sci. Mater. Med. 2012, 23, 2857–2865. [Google Scholar] [CrossRef]
- Ren, B.; Chen, X.; Du, S.; Ma, Y.; Chen, H.; Yuan, G.; Li, J.; Xiong, D.; Tan, H.; Ling, Z. Injectable polysaccharide hydrogel embedded with hydroxyapatite and calcium carbonate for drug delivery and bone tissue engineering. Int. J. Biol. Macromol. 2018, 118, 1257–1266. [Google Scholar] [CrossRef]
- Li, X.; Chen, S.; Zhang, B.; Li, M.; Diao, K.; Zhang, Z.; Li, J.; Xu, Y.; Wang, X.; Chen, H. In situ injectable nano-composite hydrogel composed of curcumin, N, O-carboxymethyl chitosan and oxidized alginate for wound healing application. Int. J. Pharm. 2012, 437, 110–119. [Google Scholar] [CrossRef] [PubMed]
- Balakrishnan, B.; Jayakrishnan, A. Self-cross-linking biopolymers as injectable in situ forming biodegradable scaffolds. Biomaterials 2005, 26, 3941–3951. [Google Scholar] [CrossRef] [PubMed]
- Balakrishnan, B.; Lesieur, S.; Labarre, D.; Jayakrishnan, A. Periodate oxidation of sodium alginate in water and in ethanol–water mixture: A comparative study. Carbohydr. Res. 2005, 340, 1425–1429. [Google Scholar] [CrossRef] [PubMed]
- Rajalekshmi, R.; Shaji, A.K.; Joseph, R.; Bhatt, A. Scaffold for liver tissue engineering: Exploring the potential of fibrin incorporated alginate dialdehyde–gelatin hydrogel. Int. J. Biol. Macromol. 2021, 166, 999–1008. [Google Scholar] [CrossRef] [PubMed]
- Höglund, E. Production of Dialdehyde Cellulose and Periodate Regeneration: Towards Feasible Oxidation Processes. Ph.D. Thesis, Karlstad University, Karlstad, Sweden, 2015. Available online: http://kau.diva-portal.org/smash/record.jsf?pid=diva2:860429&dswid=1692 (accessed on 9 March 2022).
- Reakasame, S.; Boccaccini, A.R. Oxidized alginate-based hydrogels for tissue engineering applications: A review. Biomacromolecules 2018, 19, 3–21. [Google Scholar] [CrossRef] [PubMed]
- Astudillo-Ortiz, E.; Babo, P.S.; Reis, R.L.; Gomes, M.E. Evaluation of Injectable Hyaluronic Acid-Based Hydrogels for Endodontic Tissue Regeneration. Materials 2021, 14, 7325. [Google Scholar] [CrossRef] [PubMed]
- Liu, J.; Li, J.; Yu, F.; Zhao, Y.; Mo, X.; Pan, J. In situ forming hydrogel of natural polysaccharides through Schiff base reaction for soft tissue adhesive and hemostasis. Int. J. Biol. Macromol. 2020, 147, 653–666. [Google Scholar] [CrossRef]
- Sarker, B.; Li, W.; Zheng, K.; Detsch, R.; Boccaccini, A.R. Designing porous bone tissue engineering scaffolds with enhanced mechanical properties from composite hydrogels composed of modified alginate, gelatin, and bioactive glass. ACS Biomater. Sci. Eng. 2016, 2, 2240–2254. [Google Scholar] [CrossRef]
- Kim, K.; Yeatts, A.; Dean, D.; Fisher, J.P. Stereolithographic bone scaffold design parameters: Osteogenic differentiation and signal expression. Tissue Eng. Part B Rev. 2010, 16, 523–539. [Google Scholar] [CrossRef] [Green Version]
- Zhang, L.; Liu, J.; Zheng, X.; Zhang, A.; Zhang, X.; Tang, K. Pullulan dialdehyde crosslinked gelatin hydrogels with high strength for biomedical applications. Carbohydr. Polym. 2019, 216, 45–53. [Google Scholar] [CrossRef]
- Ahn, S.-J.; Lim, B.-S.; Lee, S.-J. Prevalence of cariogenic streptococci on incisor brackets detected by polymerase chain reaction. Am. J. Orthod. Dentofac. Orthop. 2007, 131, 736–741. [Google Scholar] [CrossRef] [Green Version]
- Abedian, Z.; Jenabian, N.; Moghadamnia, A.A.; Zabihi, E.; Tashakorian, H.; Rajabnia, M.; Sadighian, F.; Bijani, A. Antibacterial activity of high-molecular-weight and low-molecular-weight chitosan upon oral pathogens. J. Conserv. Dent. JCD 2019, 22, 169. [Google Scholar] [CrossRef] [PubMed]
- Aliasghari, A.; Khorasgani, M.R.; Vaezifar, S.; Rahimi, F.; Younesi, H.; Khoroushi, M. Evaluation of antibacterial efficiency of chitosan and chitosan nanoparticles on cariogenic streptococci: An in vitro study. Iran. J. Microbiol. 2016, 8, 93. [Google Scholar] [PubMed]
- Perinelli, D.R.; Fagioli, L.; Campana, R.; Lam, J.K.W.; Baffone, W.; Palmieri, G.F.; Casettari, L.; Bonacucina, G. Chitosan-based nanosystems and their exploited antimicrobial activity. Eur. J. Pharm. Sci. 2018, 117, 8–20. [Google Scholar] [CrossRef] [PubMed]
- Anush, S.M.; Vishalakshi, B.; Kalluraya, B.; Manju, N. Synthesis of pyrazole-based Schiff bases of Chitosan: Evaluation of antimicrobial activity. Int. J. Biol. Macromol. 2018, 119, 446–452. [Google Scholar] [CrossRef]
- Yoshizaki, K.; Hu, L.; Nguyen, T.; Sakai, K.; Ishikawa, M.; Takahashi, I.; Fukumoto, S.; DenBesten, P.K.; Bikle, D.D.; Oda, Y. Mediator 1 contributes to enamel mineralization as a coactivator for Notch1 signaling and stimulates transcription of the alkaline phosphatase gene. J. Biol. Chem. 2017, 292, 13531–13540. [Google Scholar] [CrossRef] [Green Version]
- Gregory, C.A.; Gunn, W.G.; Peister, A.; Prockop, D.J. An Alizarin red-based assay of mineralization by adherent cells in culture: Comparison with cetylpyridinium chloride extraction. Anal. Biochem. 2004, 329, 77–84. [Google Scholar] [CrossRef]
- Ravindran, S.; Song, Y.; George, A. Development of three-dimensional biomimetic scaffold to study epithelial–mesenchymal interactions. Tissue Eng. Part A 2010, 16, 327–342. [Google Scholar] [CrossRef] [Green Version]

| Label | Weight Ratio | Final Concentration (w/v%) | Total Polymer Concentration (w/v%) | ||
|---|---|---|---|---|---|
| OAlg | CMC | OAlg | CMC | ||
| OAlg:CMC (4:1) | 4 | 1 | 12 | 3 | 15 |
| OAlg:CMC (3:1) | 3 | 1 | 9 | 3 | 12 |
| OAlg:CMC (2:1) | 2 | 1 | 6 | 3 | 9 |
Publisher’s Note: MDPI stays neutral with regard to jurisdictional claims in published maps and institutional affiliations. |
© 2022 by the authors. Licensee MDPI, Basel, Switzerland. This article is an open access article distributed under the terms and conditions of the Creative Commons Attribution (CC BY) license (https://creativecommons.org/licenses/by/4.0/).
Share and Cite
Mohabatpour, F.; Yazdanpanah, Z.; Papagerakis, S.; Chen, X.; Papagerakis, P. Self-Crosslinkable Oxidized Alginate-Carboxymethyl Chitosan Hydrogels as an Injectable Cell Carrier for In Vitro Dental Enamel Regeneration. J. Funct. Biomater. 2022, 13, 71. https://doi.org/10.3390/jfb13020071
Mohabatpour F, Yazdanpanah Z, Papagerakis S, Chen X, Papagerakis P. Self-Crosslinkable Oxidized Alginate-Carboxymethyl Chitosan Hydrogels as an Injectable Cell Carrier for In Vitro Dental Enamel Regeneration. Journal of Functional Biomaterials. 2022; 13(2):71. https://doi.org/10.3390/jfb13020071
Chicago/Turabian StyleMohabatpour, Fatemeh, Zahra Yazdanpanah, Silvana Papagerakis, Xiongbiao Chen, and Petros Papagerakis. 2022. "Self-Crosslinkable Oxidized Alginate-Carboxymethyl Chitosan Hydrogels as an Injectable Cell Carrier for In Vitro Dental Enamel Regeneration" Journal of Functional Biomaterials 13, no. 2: 71. https://doi.org/10.3390/jfb13020071
APA StyleMohabatpour, F., Yazdanpanah, Z., Papagerakis, S., Chen, X., & Papagerakis, P. (2022). Self-Crosslinkable Oxidized Alginate-Carboxymethyl Chitosan Hydrogels as an Injectable Cell Carrier for In Vitro Dental Enamel Regeneration. Journal of Functional Biomaterials, 13(2), 71. https://doi.org/10.3390/jfb13020071

